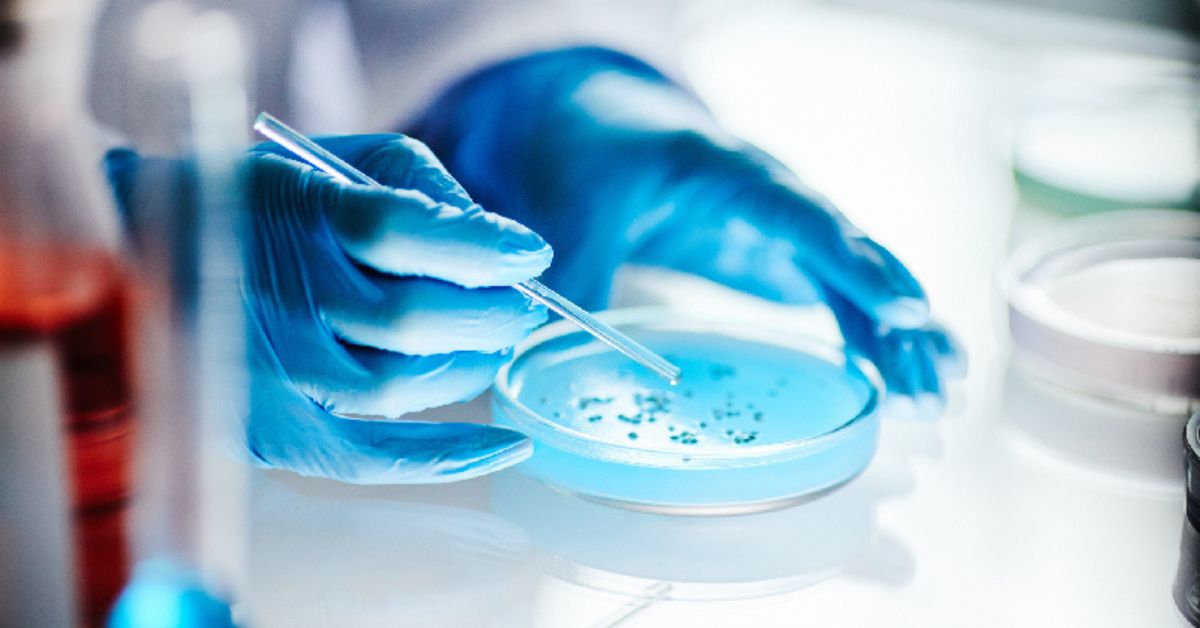
Pesquisador manipula amostra em laboratório para desenvolvimento de gel cicatrizante

O gel cicatrizante desenvolvido no Núcleo de Biologia Experimental (Nubex), da Universidade de Fortaleza, começou a ser estudado ainda em 2012 e, agora, avança rumo à produção em escala industrial. Felipe Sousa conduz a pesquisa no doutorado em Biotecnologia, sob orientação da professora Cristina Moreira. Juntos, eles transformam proteínas vegetais em formulação farmacêutica voltada à regeneração da pele.
Inicialmente, a equipe investigou propriedades da fruta-pão. Depois, em 2015, os pesquisadores passaram a combinar lectinas, proteínas capazes de se ligar a carboidratos presentes na parede celular vegetal. A partir dessa interação bioquímica, identificaram potencial de aplicação em feridas crônicas, sobretudo em pacientes com diabetes e lesões vasculares. Assim, o projeto ganhou foco clínico mais definido.
Pesquisa da Unifor e tecnologia das proteínas
Segundo Felipe Sousa, o desenvolvimento inclui a criação de hidrogéis e membranas porosas que liberam as proteínas de forma controlada na área lesionada. “A elaboração desses materiais por diferentes métodos de produção permite a elaboração de hidrogéis ou membranas porosas, capazes de carrear e liberar essas lectinas em áreas lesionadas”, afirma o doutorando.
Dessa forma, o sistema cria um ambiente favorável à regeneração de tecidos e, ao mesmo tempo, protege a área afetada. No entanto, a equipe ainda extrai a proteína ativa, chamada frutalina, diretamente da planta. Por isso, o rendimento produtivo permanece limitado.
Produção em escala e biotecnologia recombinante
Para que o gel cicatrizante chegue às prateleiras, a equipe precisa ampliar a produção da proteína. Cristina Moreira explica que a forma nativa não atende à demanda industrial. “Quando a gente pensa em transferir essa tecnologia para realmente chegar no mercado, um dos fatores limitantes é exatamente a obtenção dessa proteína nativa”, afirma.
Diante desse cenário, os pesquisadores apostam na tecnologia recombinante, amplamente utilizada na fabricação de biofármacos. Com essa estratégia, Felipe pretende criar uma startup para produzir proteínas em larga escala e desenvolver anticorpos de monitoramento. Além disso, a iniciativa pode ampliar aplicações laboratoriais e industriais.
Caminho até a indústria
Ao validar um protocolo eficiente para a forma recombinante, a equipe poderá fornecer o gel cicatrizante em escala para a indústria farmacêutica, segundo a diretora do Nubex. O centro integra o Tec Unifor e conta com apoio da Finep, o que fortalece a transição entre pesquisa acadêmica e mercado.
Se a etapa industrial avançar, a formulação cicatrizante baseada em proteína vegetal poderá se consolidar como novo insumo biomédico produzido no Nordeste. Nesse contexto, o avanço da biotecnologia aplicada à saúde reforça a aproximação entre universidade e indústria, ampliando as possibilidades de inovação terapêutica no país.ústria, com potencial de ampliar o acesso a tratamentos especializados.